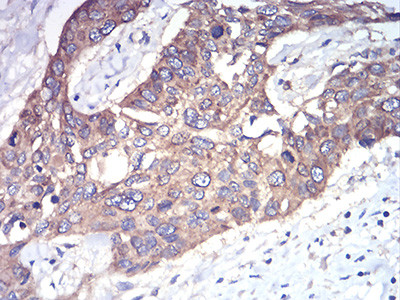
RAB1B Antibody in Immunohistochemistry (Paraffin) (IHC (P))

Search
Invitrogen
RAB1B Monoclonal Antibody (7A12G2)
{{$productOrderCtrl.translations['antibody.pdp.commerceCard.promotion.promotions']}}
{{$productOrderCtrl.translations['antibody.pdp.commerceCard.promotion.viewpromo']}}
{{$productOrderCtrl.translations['antibody.pdp.commerceCard.promotion.promocode']}}: {{promo.promoCode}} {{promo.promoTitle}} {{promo.promoDescription}}. {{$productOrderCtrl.translations['antibody.pdp.commerceCard.promotion.learnmore']}}
产品信息
MA5-31880
种属反应
已发表种属
宿主/亚型
分类
类型
克隆号
抗原
偶联物
形式
浓度
规格
纯化类型
保存液
内含物
保存条件
运输条件
RRID
产品详细信息
MA5-31880 has been tested in indirect ELISA.
靶标信息
The small GTPases Rab are key regulators of intracellular membrane trafficking, from the formation of transport vesicles to their fusion with membranes. Rabs cycle between an inactive GDP-bound form and an active GTP-bound form that is able to recruit to membranes different set of downstream effectors directly responsible for vesicle formation, movement, tethering and fusion. RAB1B regulates vesicular transport between the endoplasmic reticulum and successive Golgi compartments. Plays a role in the initial events of the autophagic vacuole development which take place at specialized regions of the endoplasmic reticulum.
仅用于科研。不用于诊断过程。未经明确授权不得转售。
生物信息学
蛋白别名: RAB1B; Ras-related protein Rab-1B; small GTP-binding protein; unnamed protein product
基因别名: RAB1B
UniProt ID: (Human) Q9H0U4
Entrez Gene ID: (Human) 81876